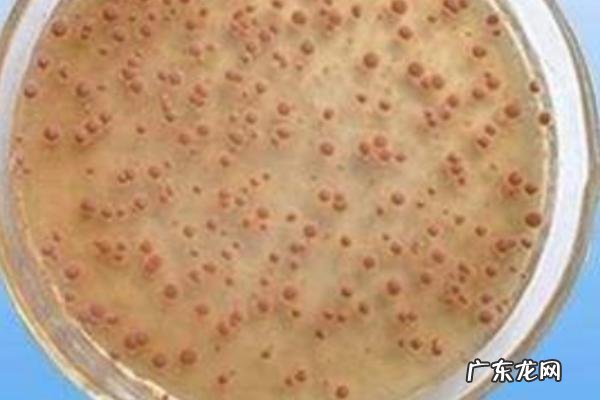

文章插图
硝化细菌放多了对鱼没害 。
硝化细菌可以转化氨氮,通过硝化细菌处理,氨氮就能被转化成为硝酸盐 。
注意硝化细菌是好氧性细菌,所以在培养过程中必须要给其爆氧 。
在投放鱼类前,首先可以在鱼缸里面加入硝化菌建立硝化系统,刚加入硝化菌时会导致水面出现短暂的浑浊状态,这时不能马上换水,等待一段时间后硝化系统就可以建立 。

文章插图
一、硝化细菌放多了对鱼有害吗
1、硝化细菌放多了对鱼没害 。这种细菌的主要作用是转化氨氮,氨氮是由水中有机物分解后产生的,它会对鱼造成毒害 。通过硝化细菌的处理,这种物质就可以被转化成为硝酸盐 。
【硝化细菌放多了对鱼有害吗】
文章插图
2、需要注意的是,硝化细菌属于好氧性细菌,所以在培养过程中一定要爆氧,否则水体溶氧不足就会导致鱼儿浮头 。
3、在投放鱼类前,首先一定要在鱼缸里面加入硝化菌建立硝化系统 。刚加入硝化菌时水会出现短暂的浑浊状态,这时一定不要贸然进行换水 。当等待一段时间后,硝化系统就能建立完成,这时它们可以起到良好的净化水质作用 。

文章插图
二、硝化细菌的使用方法
1、选择合适的硝化菌:首先,要去商店购买硝化菌 。目前硝化菌种类有液体的硝化菌,硝化菌胶囊,它们有之间一定的差异 。液体的硝化菌效率比较快,硝化菌胶囊的纯度会更高一些,可以根据自己的需要购买 。
2、提供适宜的繁殖环境:每10毫升硝化细菌用于70升水即可,如果是新的鱼缸,在前2周内,每7天放10毫升硝化细菌用于35升水中,2周以后,可以按正常使用量 。在放入硝化菌之后,要给它们提供一个适宜的环境 。比较重要的一个因素是水温,水温一定要保持在25°C左右,这样有利于它们繁殖 。PH值也要重视,一定要为其提供一个弱碱性的环境,水中还需要有足够的氧气 。

文章插图
3、时间:在调节好环境之中,一定要耐心等待,因为形成完善的硝化菌系统是一个很漫长的过程,有时需要等待1个多月 。
- 鲜虾怎么保存为最新鲜
- 骨头汤里放什么食材好
- 月饼要不要放冰箱保存
- 芒果能放冰箱保鲜吗
- 10斤梨放多少川贝粉做秋梨膏
- 白鞋怎么放置不发黄
- 顺丰快递可以放到菜鸟驿站吗?
- 热饭菜放进冰箱可以吗
- 汉堡怎么加热比较好
- 2023年五一放假哪两天调休 2023年五一劳动节放假几天
特别声明:本站内容均来自网友提供或互联网,仅供参考,请勿用于商业和其他非法用途。如果侵犯了您的权益请与我们联系,我们将在24小时内删除。
